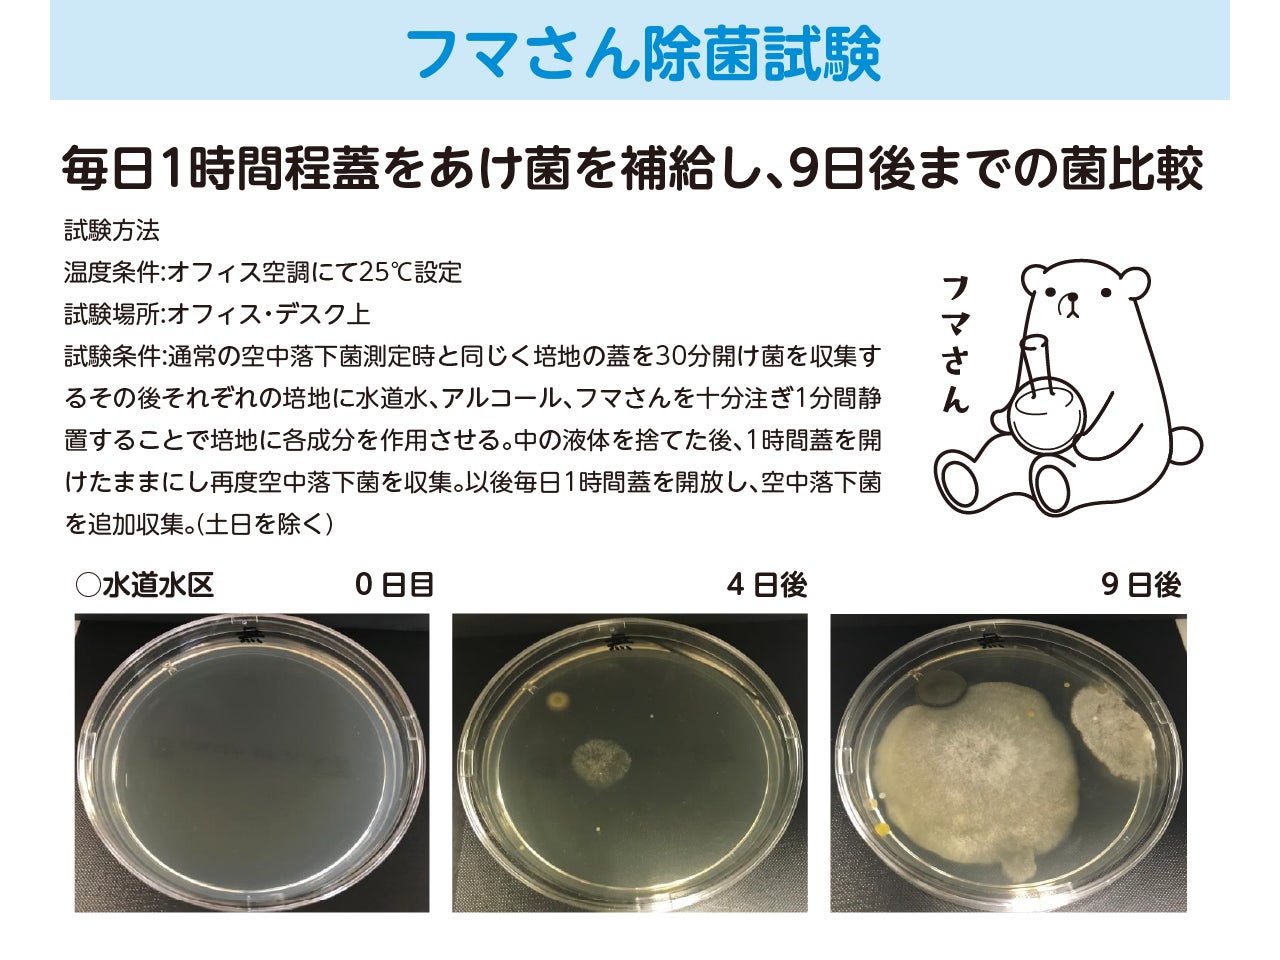
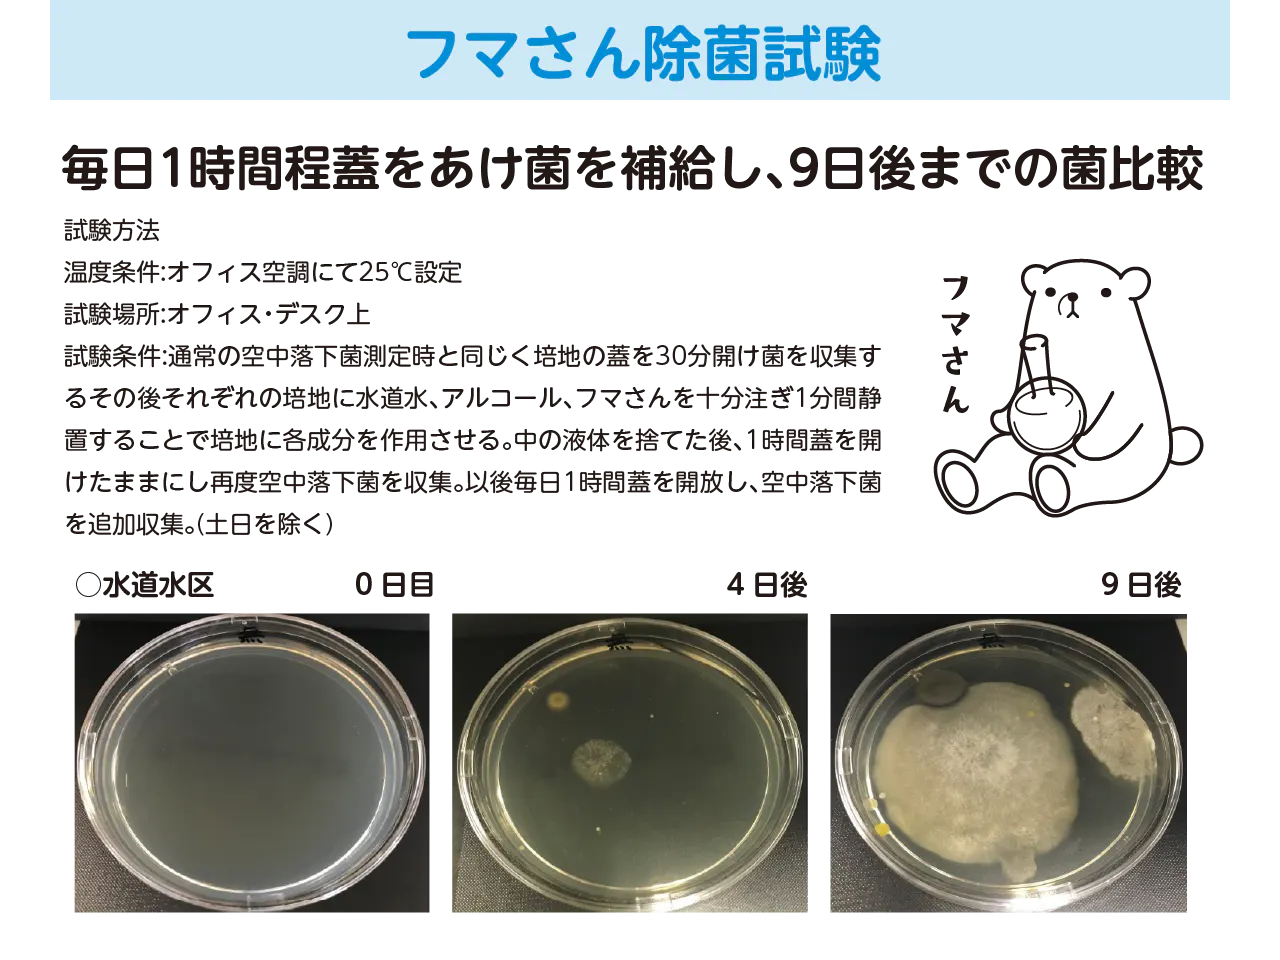
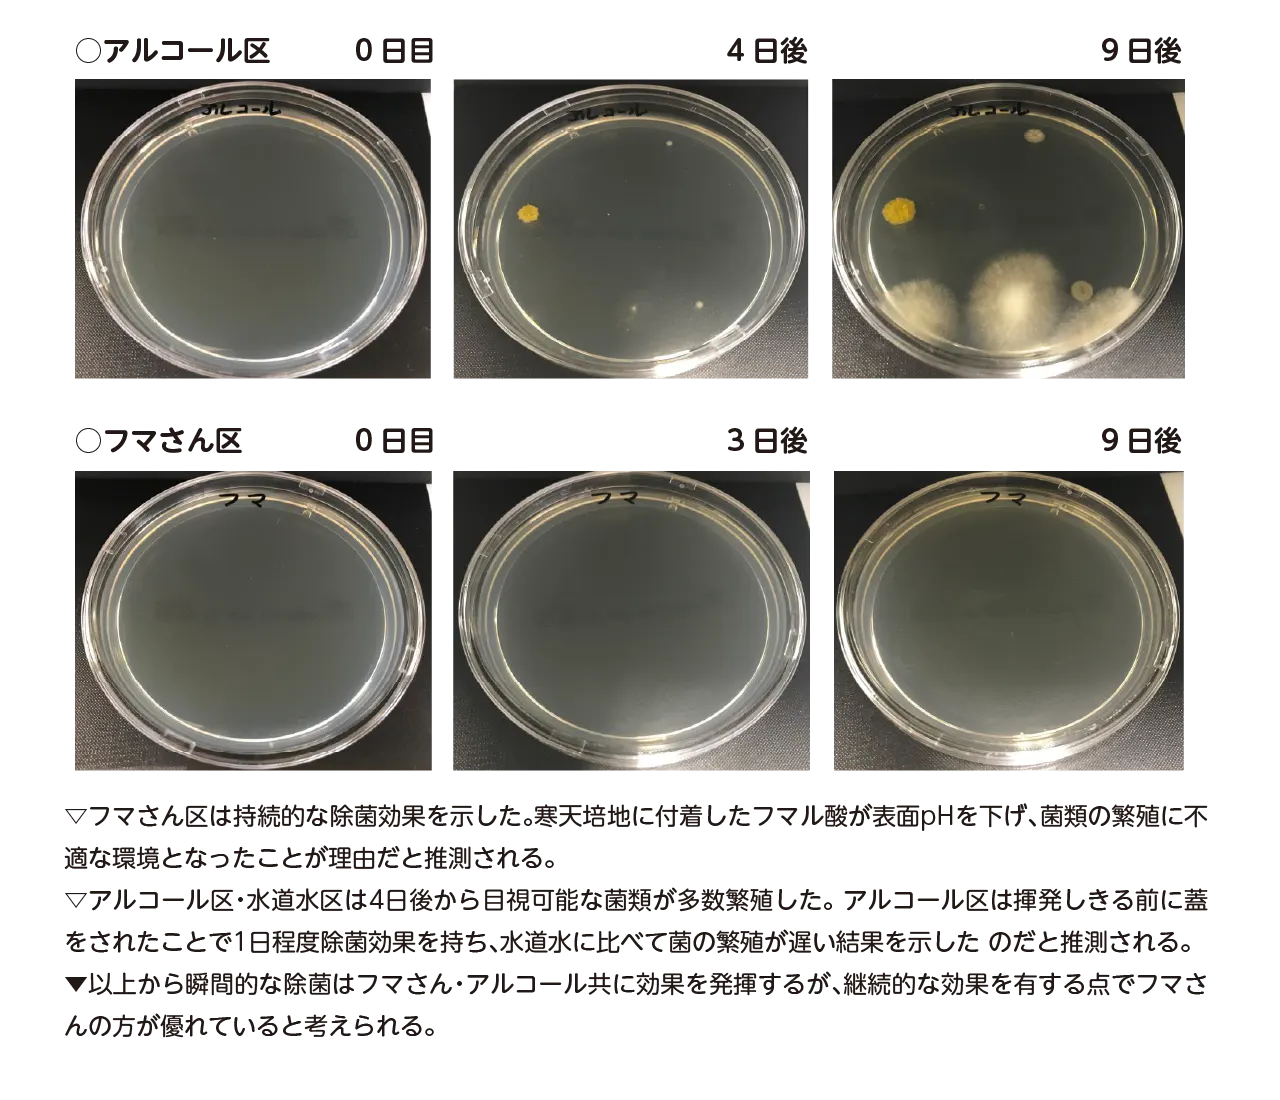
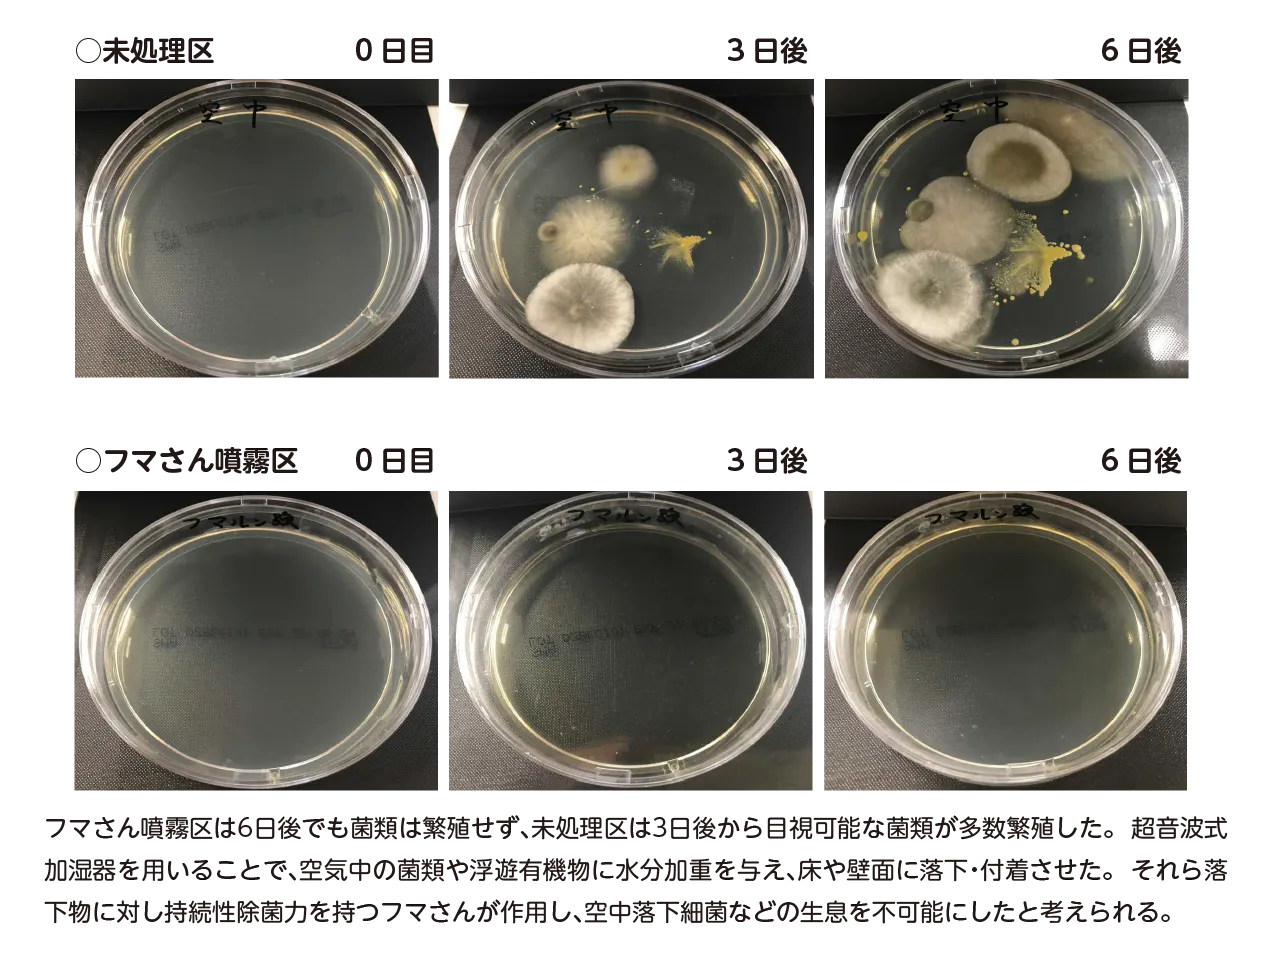

お持ちの「超音波加湿器に少し加えるだけ」で空気中に浮遊する菌を落として除菌し、菌に由来するニオイも消臭。
天然以上に安全な除菌液【フマさん】は、効果が長く、手肌にやさしい、空間噴霧から手元除菌まで使える日本製の除菌液です。
オフィスやご自宅で安心して過ごすために除菌が欠かせない昨今。
塩素系成分やアルコール配合の除菌剤を使用しているけれど体への影響や肌荒れが心配。
そんな方に、
人の体内で生成される安全性の高い成分フマル酸等のフルーツ酸を配合した除菌液「フマさん」
を開発しました。食品添加物にも使用されるほどの安全性の高さと確かな除菌力を持ち、食品やおもちゃにかかっても大丈夫。菌に由来するニオイも消臭します。小さなお子さまやご年配の方、ペットがいる空間でも安心してお使いいただけます。超音波加湿器には50倍希釈して使うので経済的です(手元除菌にスプレー使用は2倍希釈)。
主成分のフマル酸に親しんでただけるよう、フマル酸を使っていろんなモノを守る妖精
新しいキャラクターキャスト「フマさん」が登場。
これから フマさんが悪い菌やウイルスを除菌する世界をご案内します。
【フマさん】のある日常
■リビングで

大切なご家族が集まるリビングやダイニングは、常に除菌が必要です。 安全に効果が持続する除菌ができないか? アルコール系は吹いた直後は除菌できてきるが、しばらくすると菌が付着しても、除菌ができないし。。。そんな時はフマさん。フマさんは、ダイニングテーブルなどの物体表面を拭き取ると、吹いた後にフマル酸が表面にのこり効果が持続。お手入れ後も長時間安心して、お過ごしいただけます。
フマさんは、拭き取り後も、皆様のために、菌やウイルスの繁殖を防いでくれます。
■お出かけ前に

屋外から屋内への菌やウイルスの持ち込みを防ぎたい。。
その場合、
お出かけ前にフマさんをつけておきます。
帰宅時にできるだけ、物体表面での繁殖を防ぐことが重要です。
マスク表面・衣服・カバンに、スプレーでフマさん噴霧すると、フマさんは、外出先でも、マスク・衣類・カバンなどの表面で菌やウイルスから守ります。
■オフィスで

多くの人が働くオフィス。
テスクトップで小型の超音波加湿器やディフューザーを使い保湿されている方も多いと思います。
その水道水の中に2%のフマさんを滴下すると、フマさんは、周囲に拡散し、
物体表面の菌やウイルスを退治するとともに、そのまま表面にのこり、新たに付着した菌も退治します。
会社オーナーや管理職の方、リモートワークを薦めていても、部署によってどうしても出社し、オフィスで仕事が必要な場合、フマさんが安全に皆様をお守りします。
■店舗でも

飲食店・食品・商品販売をされる店舗の方へ
入店時:
入口にアルコール消毒液をを義務付けておられるところがほとんどですが、お客様によってはアルコールの肌荒れが気になる方や、複数の店舗を周りその度に消毒を行わなければならず、辟易されている方も少なからずおられます。
また、お客様が店舗内で、さまざなところや商品を手に触っておられますが、全てを除菌することは大変困難です。
フマさんは、水溶液、しかも、そもそも皮膚内で生成されるフマル酸と同じものが主成分です。また、超音波加湿器使用により、店内表面の隅々まで長期間の除菌が持続します。
お客様に安心して、店内でお過ごしいただけます。
フマさんが、お店を守っていることをお知らせするステッカーを作りましたので、是非ご活用ください。
■帰宅時に

帰宅時玄関で、外部からの菌の持ち込みを防ぐのにもフマさんは活躍します。
外出時にフマさんをあらかじめ噴霧するのは効果的です。帰宅時に、付着している菌が少なくなっています。さらに、玄関先で、超音波加湿器で噴霧したり、スプレーで噴霧することで、より効果的です。ご自宅内への菌・ウイルスの持ち込みを効果的に防ぎます。
■ご家庭でお子様や受験生に

これから、秋・冬と季節がかわり、空気が乾燥します。菌やウイルスが、飛散しやすく、鼻・喉の粘膜に付着しやすくなります。
超音波加湿器を使用することで、空気の加湿を防ぎますが、そこにフマさんを少し加えるだけで、お部屋の表面の除菌ができます。
フマさんは大切な方の大切な時をお守りします。
フマさん 6つの特徴

除菌した後も効果が持続
拭いたり吹き付けた後も成分が残るので除菌効果が長もち。除菌の回数も減らせます。

寒天培地にフマさん(フマルン)とアルコールを十分に吹きかけ、除菌水層が無くなるまで乾燥させ成分が培地に付着した後蓋を閉め菌を培養。

検査実施機関 日曹商事株式会社 https://www.nissoshoji.com/jp/
検査地 〒103-0023 東京都中央区日本橋本町3丁目3−6
検査実施時期 2021年6月28日~7月7日
検査内容と結果
寒天培地にフマさんと他比較を十分噴霧し、各液を十分乾燥させた後フタをした。対象区ではフタをするまでに培地へ落下したカビや黄色ブドウ球菌が増殖したものの、フマさん処理区は菌類が繁殖しなかったので持続性除菌能力を有することが示された。

天然以上の安全性
「食品添加物と同じ成分」で「体内でも生成される」フマル酸を使用した、水溶液で安全性能&効果の高い除菌液をお手元に。アルコール刺激が苦手な方にも安心して利用いただけます。
ヒトの肌は日光に晒されると自然にフマル酸を生成します。このフマル酸が主成分の水溶液「フマさん」は、噴霧することで空間に浮遊するや菌や身の回りのウイルスをキャッチし床などに落としで除菌。さらに噴霧後に「フマさん」が付着した床や壁にも長い除菌効果を発揮します。

高い安全性で安心してお使いいただけます
業務用で活躍の食品添加物製剤フマルンと同等製品を一般消費者向けにご提供。体内で生成される有機物と同じ成分で安心な上、除菌に効果的。

「フマさん」は有機酸
主要除菌成分の特徴
有機酸 → 酢酸やアスコルビン酸、フルーツ酸など
〇:有機物存在下でも有効。強力な防御力を持つ芽胞菌にも効果的。塩素系・アルコール系に比べ持続性がある
塩素系 → 次亜塩素酸Na or Ca、次亜塩素酸水など
〇:安価。ノロウイルスを含めて広い効果範囲を持つ
アルコール系 → 医薬用部外品(免税)、雑貨(免税)、食品用(課税)
〇:速乾性。免税品は安価。塩化ベンザルコニウム等を足して効果を高められる。
実証実験で証明された高い除菌力
食中毒を引き起こす菌・細菌類に対する実証データ

検査実施機関 熊本県産業技術センター https://www.kumamoto-iri.jp/
検査地 〒862-0901 熊本県熊本市東区東町3丁目11−38
検査実施時期 2020年11月30日~11月30日
検査内容と結果
1,000,000/ml以上の菌数液に対しフマさんを接種即時・30秒・1分・2分・3分作用させ、その後寒天培地に塗布し培養。およそ20時間後の菌数を測定した結果、フマさんは接種直後に除菌効果を発揮したことが示された。

「生地に50倍希釈のフマさんを吹きかければ100g生地あたりフマル酸0.003gが付着し、抗菌活性値5.4を示します(抗菌活性値2.0以上で99%以上の除去率/主成分ノリエール[溶解性改善フマル酸]で試験)」
検査実施機関 日曹商事株式会社 https://www.nissoshoji.com/jp/
検査地 〒103-0023 東京都中央区日本橋本町3丁目3−6
検査実施時期 2021年5月27日~6月2日(フマルン噴霧)/6月3日~6月9日(水噴霧)
検査内容と結果
フタをあけた寒天培地に対し、加湿器にてフマさんならびに水を試験期間中連続噴霧。無処理区は30分蓋を開放し、蓋を閉めた後6日間静置。フマさんを噴霧した場合は培地へ落下したカビや黄色ブドウ球菌を除菌・抑制することが示された。

超音波加湿器や超音波ディフューザーで簡単に使えます
人気の超音波加湿器や超音波ディフューザーに2%混ぜるだけ(250ccの水に小さじ一杯5cc)で浮遊する菌などを落下させ除菌。快適空間に。気になるご家庭やオフィス空間に最適な高除菌力を発揮する製剤が食品添加物と同じ成分で登場!どんなメーカーの噴霧器具でも超音波系ならOK。高い除菌力を発揮します。


食品添加物と同じ成分使用なので匂いも気にせず使えます
空間噴霧も拭き取りもあの嫌な匂いが残らない。「食品添加物と同じ成分」で「体内でも生成される」フマル酸を使用しているので、匂いもやさしく除菌後は消臭効果も発揮。気になるマスクの臭い消しなどにもぴったりです。


噴霧 2%を水道水に混ぜるだけ。
お手持ちの超音波式の加湿器・ディフューザーがそのままお使いいただけます。
タンク容量100mlの加湿器なら190回分!
※380mlパッケージ利用時

スプレー 2倍希釈で使用
効果が長く続くので拭き直しの回数が少なくて済みます。

フマさんステッカー
フマさんを噴霧いただいている空間に目印としてステッカー貼付で安心

【オフィスのエアコン対策に合わせて】

【ご家庭の空間を安全に除菌したい方に】

【小さなお子様がいるご家庭も】

【大事なペットがいる場所でも】

【絶対に体調を崩せない方のいる場所に】
介護施設や

受験勉強のお子様の部屋にも

【お店の空間中に浮遊する菌類を落として除菌】

使い方
だれでも簡単安全使用
使い方は簡単、用途に応じて薄めて利用するだけです。噴霧にはキャップだけで簡単に計量できます。
空間除菌に
超音波ディフューザーや超音波加湿器で

超音波ディフューザーや超音波加湿器にはフマさんを「50分の一」入れて使用します。容量に応じ調整してください。
例)200mlならキャップ約一杯(4ml)
※入れすぎても体に悪影響はありません。

拭き取り除菌に
テーブルや家具を拭きたい時にはスプレーボトルで1:1の割合に
※瞬時+持続的な効果を期待する場合はアルコールと1:1で利用も利用可能です。


冷蔵庫内も拭き取りで清潔除菌


車のシートの除菌&消臭効果も

製品仕様
・品名:フマさん
・用途:除菌清掃・空間除菌衛生管理
・成分表示:フマル酸0.4% 安息香酸Na 0.1% クエン酸0.01% リンゴ酸0.01% 乳酸Na 0.01% グリセリン脂肪酸エステル 0.006% キサンタンガム0.002% 水
・内容量:380ml
・有効期限:製造年月日より2年(開封前)
・製造:株式会社バイロン
・販売:テクノゲートウェイ株式会社
【日本製】
・使用上の注意事項:
○アルカリ系の製品(次亜塩素酸ナトリウムなど)との混合は避けてください。
○成分が分離し、沈降することがありますので、使用前には良く振ってから使用してください。
○本製品はレモン果汁と同等の酸性製品です。金属製品(鉄、ブリキ、銅など)は錆びる恐れがありますので、使用後は速やかに水で洗い流してください。
・保管及び取扱上の注意事項:
○密栓して冷暗所に保管してください。
○開封後はなるべく早く使い切ってください。
・応急処置
○目に入った場合は、直ちに大量の水で洗眼し、異常の時は医師の診断を受けてください。
アレルギー物質(27品目中):該当なし
リターンについて

資金使途
安心安全をお届けする製品の研究開発
初期量産ロット材料の調達
CAMPFIRE手数料
と考えています。
これからも製品開発に邁進する所存ですので、お力添えの程何卒よろしくお願いいたします。
実施スケジュール
2021年8月24日(火) プロジェクト開始
2021年9月15日(水) プロジェクト終了後、製造開始
2021年10月中の配送

「 日本製ポテンシャルを解き放て、いいものラボ始動 」
ご一緒に日本製のポテンシャルの解放しましょう。多くの技術製品が素晴らしくても成功しない。技術的に優れた製品で使った人には高い評価でも認知度が低くあまり売れず製造中止に。少なからずこのような技術・製品があります。マーケティング全盛の時代、社会保険料・税金が少なく、電気代や環境対策コストの低い国で生産した低価格の製品を海外から持ってきて、開発費負担0、綺麗に撮影、体裁よくプロモーション、大ヒット製品、大ブランドに。日本にとってこれで良いのでしょうか? これが数十年続いて、日本製ブランドの相対的競争力の低下、日本の雇用環境悪化・理系人材の減少・国力衰退。これでは日本が育ちません。一緒に日本製造のポテンシャルを解き放ちたい。
「 いいものを開発×良さをお伝えする = お客様が使う喜びを最大化 」
テクノゲートウェイ株式会社と株式会社無限が共同で実現を目指すコンセプトブランドとして、2021年6月より始動しました。日本を中心に厳選された素材と技術を解りやすく使いやすいデザインでお届けいたします。今回は「フマさん」をお届けします。 これまで、テクノゲートウェイ株式会社の早川が一人で、研究・開発・デザイン・マーケティング・製造・販売・サポートを行ってきましたが、お客様との重要な接点であるデザインについて株式会社無限と提携し、よりご満足のいただける製品を提供いたします。
・技術開発/技術発掘 : テクノゲートウェイ株式会社
・デザイン : 株式会社 無限
・初期費、初ロット : キャンプ ファイヤー クラウドファンディング、サポーターの皆様
いいものラボ製品化・事業化へ。 この流れをご一緒に大きくしていきましょう!

皆様のおかげで創業10年目を迎えることができました。千葉県木更津市の化学で快適を実現する企業です。
ここまでの道のりには色々なことがありました。 創業は2011年10月。そうです。この年は3月に東日本大震災があり、突然日常が日常ではなくなることを思い知らされました。 限りある人生、悔いなく皆様のお役に立ちたいとテクノゲートウェイ株式会社を立ち上げました。当初はタイランドに子会社を設立しHDD向けに日本の高性能樹脂をタイランドに輸出しておりましたが、SSDの台頭やダウンサイジングで市場縮小。2017年に子会社を売却し日本で化学の知見を応用した新製品の開発にチャレンジしました。 木更津市・千葉県の地域の方々から人的資金的に多大なるご支援をいただき、かずさインキュベーションセンターで、柔らか珪藻土等数々の新製品開発を実現し、クラウドファンディングでご支援を募りました。
これまで15プロジェクト総額約2900万円。多くのサポーター様に支えられ、おかげさまでこのたび革新的製品を開発することができました。
気がつけば今年で創業10年目。これからも皆様の快適の一助となるような新製品開発を続けて参りたいと存じます。また、本プロジェクト開始前に、サポーターの皆様にアンケートをお答えいただき、仕様検討に大いに参考とさせていただきました。誠にありがとうございました!
木 更 津 市 商 工 会 議 所 優 良 会 員 企 業 表 彰 い た だ き ま し た !

中小企業庁千葉県よろず相談拠点 代表的事例に採用
クラウドファンディングを行う際に、製品のコンセプト・キャッチフレーズ・トップのキービジュアル作成等度重なる多大なご支援をいただきました。
リスク&チャレンジ
※不具合がある場合、商品到着より1週間以内に写真を送付いただき、原因の特定を行い、代替品を送付いたします。
※本プロジェクトを通して想定を上回る皆様からご支援を頂き、現在進めている環境から量産体制を更に整えることができた場合、正規販売価格が販売予定価格より下がる可能性もございます。
※開発中の製品につき、デザイン・仕様が一部変更になる可能性もございます。
※ご注文状況、使用部材の供給状況、製造工程上の都合等により出荷時期が遅れる場合があります。
クラウドファンディングの性質上、以上の注意点につきましてあらかじめご理解とご了承いただいた上でご支援くださいますよう、よろしくお願い申し上げます。
<募集方式について>
本プロジェクトはAll-in方式で実施します。目標金額に満たない場合も、計画を実行し、リターンをお届けします。
■ 特定商取引法に関する記載
◯ 販売事業者名: テクノゲートウェイ株式会社
◯ 事業者の所在地:〒292-0814 千葉県木更津市八幡台4−4−7
◯ 事業者の連絡先:Tel: 050-3390-8166 メール: cu@techno-gateway.asia
※こちらでは当該製品に対するお申し込み、質問等は受け付けておりません。
◯ 商品の販売価格・役務の対価:各リターン記載のとおり
◯ 対価以外に必要な費用:プロジェクトページ、リターンに記載のとおり
◯ 申込期限:当ページ記載のプロジェクト終了期限どおり
◯ 代金の支払時期:
各プロジェクトが募集期間内に成立した時点で、支援金の決済が行われます。コンビニ払いは、コンビニエンスストアで所定の方法により支払いが完了した時点で、決済が行われます。銀行振込(ペイジー払い)は、ATMまたはネットバンキングにて所定の方法により支払いが完了した時点で、決済が行われます。auかんたん決済、ソフトバンクまとめて支払い・ワイモバイルまとめて支払い、ドコモ払い、PayPal、FamiPay、PayPayは、各決済画面により支払いが完了した時点で決済が行われます。
◯ 支払方法:
クレジットカード払い(Visa/Mastercard/JCB/Diners Club/American Express)/コンビニ払い(全国の主要コンビニエンスストア)/銀行振込(銀行ATM・ネットバンキング)/auかんたん決済/ソフトバンクまとめて支払い・ワイモバイルまとめて支払い/ドコモ払い/PayPal/FamiPay/PayPay。お支払いの手数料に関して、コンビニ払いの場合 350円(税込)が、お客様のご負担となります。また、銀行振込ご利用の場合は、所定の振込手数料がお客様のご負担となります。
◯ 商品引渡しまたは役務提供の時期:各プロジェクトが募集期間内に成立した場合のみ、支援金の決済が行われ、約定されたリターンを得る権利が発生します。なお、リターン毎の発送(履行)時期は各プロジェクトの記載・連絡に準じます。諸般の事情により遅延・遅配が生じる場合は、プロジェクトオーナーより記載・連絡されるものとします。
◯ キャンセル・返品: 利用規約記載のとおり、お客様都合による返品・キャンセルはできませんのでご注意ください。尚、製品到着後に破損や初期不良がある場合には交換させていただきますので「メッセージで意見や問い合わせを送る」から、または納品書記載の連絡先までお問い合わせください。
※上記以外の事項に関しては、お取引の際に請求があれば遅延なく提示いたします。
最新の活動報告
もっと見る【新色登場!】3秒で快適、1時間でほぼ乾燥する珪藻土傘グッズ「casara & casara case2」プロジェクト開始のお知らせ
2025/08/08 06:52いつもご支援いただき、誠にありがとうございます。この度、皆様からのご要望にお答えして、大好評をいただいている珪藻土傘グッズ「casara」に新色が登場いたします!ついに6色展開が実現!これまでの高い性能はそのままに、「もっと色の選択肢が欲しい」というお声にお応えして、以下の6色をご用意いたしました:ベージュ、グレイ、グリーン、レッド、ネイビー、ブラックお気に入りの色で、毎日の傘ライフをもっと楽しく彩れます。変わらぬ高性能 *3秒で快適:傘をさっと立てるだけ *1時間でほぼ乾燥:珪藻土の優れた吸水力 *防カビ効果:いつも清潔に保てます明日まで(8月9日まで)のご支援限定特典今回のプロジェクトでは、早期ご支援の皆様に2つの特典をご用意いたします:特典1:スペアインナー無償同梱応援コメント欄に「テクノゲートウェイ株式会社リピーターです!」とご入力いただいた方には、スペアインナーを無償で同梱いたします。特典2:Creemaポイント10%プレゼント8月7日(木)~8月9日(土)の期間中にCreema SPRINGSでご支援いただいた全ての方に、Creemaで使えるポイント10%分をプレゼントいたします。プロジェクト詳細Creema Springsにてプロジェクト開始中です:https://www.creema-springs.jp/projects/techno-casaraポイントキャンペーン詳細:https://www.creema.jp/campaign/point/20250807_creemasprings皆様のご支援のおかげで、より魅力的な商品をお届けできることを心より感謝しております。この機会をぜひお見逃しなく、新しい「casara」をお手に取っていただけますと幸いです。今後ともどうぞよろしくお願いいたします。 もっと見る【期間限定】いつものご愛用者様へ、心からの感謝を込めて 特別にLサイズを1枚プレゼント!
2025/07/24 08:04皆様の温かいご支援のおかげで、シルフィーノバスマットはたくさんのご家庭で愛され続けています。その感謝の気持ちを、何か形にしてお返ししたい…そんな想いから、今回特別なキャンペーンをご用意いたしました。【いつものサポーター様だけの特別特典】新しいCampfireプロジェクトにご参加いただくと、通常のリターンに加えて「シルフィーノバスマットLサイズ」を1枚、感謝の気持ちを込めて無料でお付けします!【特別期間】2025年7月24日(木)~7月26日(土)の3日間限定【参加方法はとっても簡単】下記プロジェクトにご支援応援コメント欄に「テクノゲートウェイのリピーターです」と一言よろしければ、いつもお使いいただいている感想も教えてください♪プロジェクトはこちら▼https://camp-fire.jp/projects/868728/view脱衣場、洗面所用、玄関用、キッチン用に …※おすすめは、椅子のシートとして使用すると、お尻や太もものムレを大幅軽減 この時期 特に快適に!ご家族への贈り物に…お友達にもおすすめしたい時に…この機会に、ぜひもう1枚お手元に置いていただけたら嬉しいです。皆様の日々の暮らしが、少しでも快適になりますように。そして、これからも末永くお付き合いいただけますように。心を込めて、感謝とともに。ご検討の程何卒宜しくお願い致します!プロジェクトURL:https://camp-fire.jp/projects/868728/view もっと見る
5分サラサラ!洗濯機で丸洗いOK!【シルフィーノ2】プロジェクトご案内
2025/04/07 11:00大変お世話になっております。この度は、3点のご案内をさせていただければと存じます。1 【Makuake推奨実行者】に認定!Makuakeでは8年間で30種以上の新製品を創造し、8,000名を超える皆様に支えられてきました。この度、評価と経験が認められ【Makuake推奨実行者】に認定!これもひとえにサポーター様のおかげです。誠にありがとうございます。2 5分サラサラ!洗濯機で丸洗いOK!【シルフィーノ2】昨年シルフィーノプロジェクトが、これまでのMakuakeバスマットプロジェクトの中で最も多くの応援を4.6の高評価とともにいただくことができました。感謝と共に、部材をオールジャパン 課題の滑りやすい、さらにサラサラ感を改善し、この度【5分でサラサラ】シリカゲルの力で驚きの速乾力。家族みんなで使っても、吸水力が落ちない。【らくらくお手入れ】洗濯機でサッと丸洗い、お手入れ時短。嫌なゴムのニオイとはおさらば!【清潔さが長続き】シリカゲルの調湿性がカビの心配を減らします。清潔は足もとから。5分サラサラ!吸水力が落ちない!洗濯機で丸洗いOK!【シルフィーノ2】https://www.makuake.com/project/silphino2/プロジェクトスタートです。4月9日までに応援購入いただき、「テクノゲートウェイリピーターです」と応援コメントを投稿いただいた方に、当社一押し 無香料 アミノ酸 消臭除菌剤【滅臭王】を100ml 同梱プレゼントいたします!是非プロジェクトをご覧いただければ幸いです。3 「どこでも水素水 〜Hydrogen stick〜」この度、クラウドファンディング 「どこでも水素水 〜Hydrogen stick〜」 をパートナー企業のRITA にてスタートいたしました。https://camp-fire.jp/projects/829602/viewRITA様のご厚意でテクノゲートウェイサポーター様限定特典をつけていたけることになりました。どこでも水素水プロジェクトを ご支援いただき、応援コメントに 「テクノゲートウェイリピーターです」 とご記入いただいた方限定で、「1週間分(1gスティック7本)」をプラスアルファでお付けいたします。是非こちらのプロジェクトもご覧いただければ幸いです。何卒宜しくお願い致します。テクノゲートウェイ株式会社 代表取締役 早川 昇 もっと見る













コメント
もっと見る